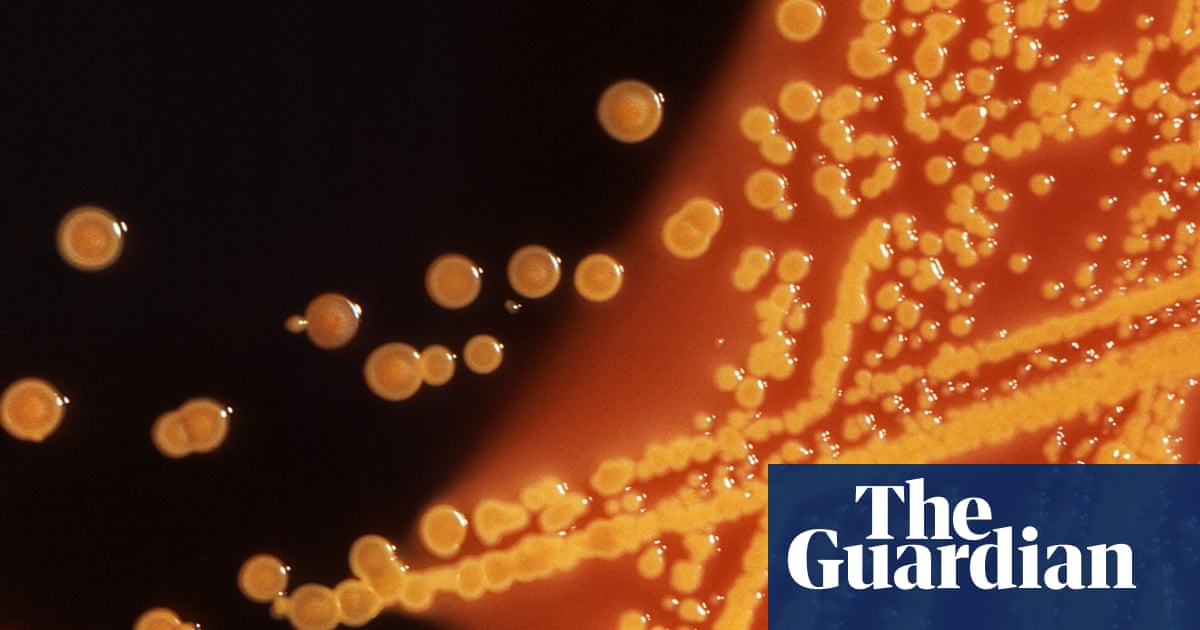
Cambridge scientists create world’s first living organism with fully redesigned DNA | Science | The Guardian

Scientists have created the world’s first living organism that has a fully synthetic and radically altered DNA code.
The lab-made microbe, a strain of bacteria that is normally found in soil and the human gut, is similar to its natural cousins but survives on a smaller set of genetic instructions.
The bug’s existence proves life can exist with a restricted genetic code and paves the way for organisms whose biological machinery is commandeered to make drugs and useful materials, or to add new features such as virus resistance.
In a two-year effort, researchers at the laboratory of molecular biology, at Cambridge University, read and redesigned the DNA of the bacterium Escherichia coli (E coli), before creating cells with a synthetic version of the altered genome.
What is gene editing and how can it be used to rewrite the code of life?
Read more
The artificial genome holds 4m base pairs, the units of the genetic code spelled out by the letters G, A, T and C. Printed in full on A4 sheets, it runs to 970 pages, making the genome the largest by far that scientists have ever built.
“It was completely unclear whether it was possible to make a genome this large and whether it was possible to change it so much,” said Jason Chin, an expert in synthetic biology who led the project.
The DNA coiled up inside a cell holds the instructions it needs to function. When the cell needs more protein to grow, for example, it reads the DNA that encodes the right protein. The DNA letters are read in trios called codons, such as TCG and TCA.
Nearly all life, from jellyfish to humans, uses 64 codons. But many of them do the same job. In total, 61 codons make 20 natural amino acids, which can be strung together like beads on a string to build any protein in nature. Three more codons are in effect stop signs: they tell the cell when the protein is done, like the full stop marking the end of this sentence.
The Cambridge team set out to redesign the E coli genome by removing some of its superfluous codons. Working on a computer, the scientists went through the bug’s DNA. Whenever they came across TCG, a codon that makes an amino acid called serine, they rewrote it as AGC, which does the same job. They replaced two more codons in a similar way.
More than 18,000 edits later, the scientists had removed every occurrence of the three codons from the bug’s genome. The redesigned genetic code was then chemically synthesised and, piece by piece, added to E coli where it replaced the organism’s natural genome. The result, reported in Nature, is a microbe with a completely synthetic and radically altered DNA code. Known as Syn61, the bug is a little longer than normal, and grows more slowly, but survives nonetheless.
“It’s pretty amazing,” said Chin. When the bug was created, shortly before Christmas, the research team had a photo taken in the lab with a plate of the microbes as the central figure in a recreation of the nativity.
Such designer lifeforms could come in handy, Chin believes. Because their DNA is different, invading viruses will struggle to spread inside them, making them in effect virus-resistant. That could bring benefits. E coli is already used by the biopharmaceutical industry to make insulin for diabetes and other medical compounds for cancer, multiple sclerosis, heart attacks and eye disease, but entire production runs can be spoiled when bacterial cultures are contaminated with viruses or other microbes. But that is not all: in future work, the freed-up genetic code could be repurposed to make cells churn out designer enzymes, proteins and drugs.
4:22
In 2010, US scientists announced the creation of the world’s first organism with a synthetic genome. The bug, Mycoplasma mycoides, has a smaller genome than E coli – about 1m base pairs – and was not radically redesigned. Commenting on the latest work, Clyde Hutchison, from the US research group, said: “This scale of genome replacement is larger than any complete genome replacement reported so far.”
“They have taken the field of synthetic genomics to a new level, not only successfully building the largest ever synthetic genome to date, but also making the most coding changes to a genome so far,” said Tom Ellis, a synthetic biology researcher at Imperial College London.
But the records may not stand for long. Ellis and others are building a synthetic genome for baker’s yeast, while Harvard scientists are making bacterial genomes with more coding changes. That the redesigned E coli does not grow as well as natural strains is not surprising, Ellis added. “If anything it’s surprising it grows at all after so many changes,” he said.
This content was originally published here.